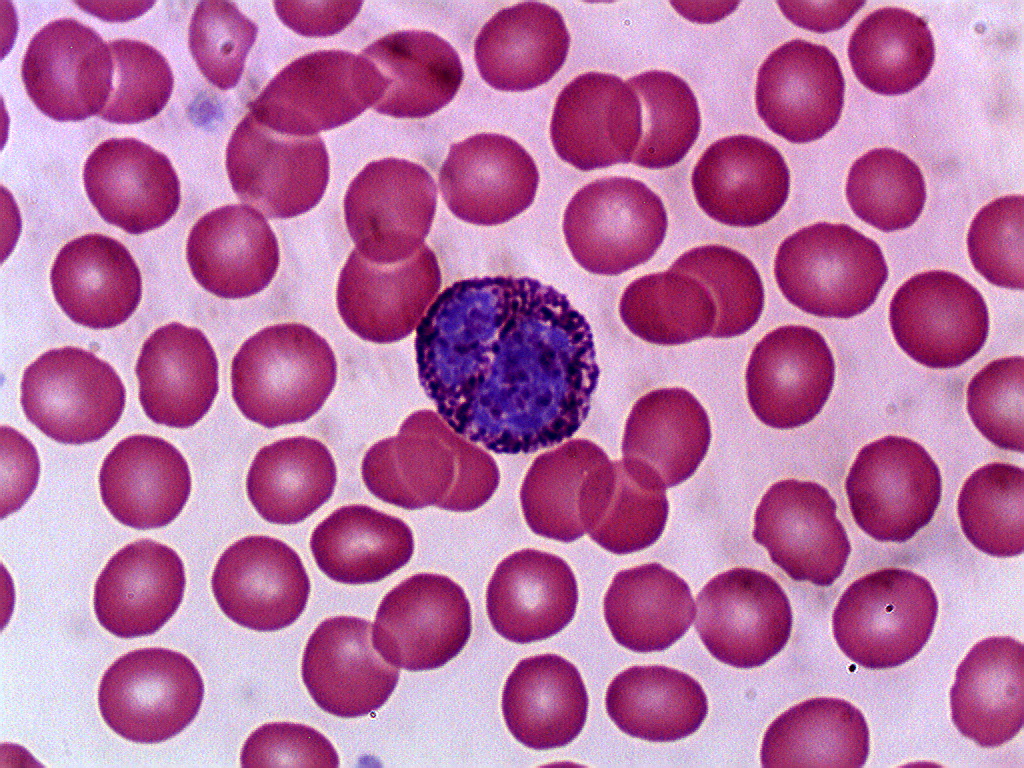

Число базофилов
Временный постоянный предложения
Какая закономерность наблюдается по периоду изменения
Велотренажер рязань
В алтайском крае выпал снег 2024
Математика 5 кл 1.209
Жу ма пель
Полиуретановая рама
Need for speed app
35 x 1 81
Вф ранхигс бывш
Уменьшение сфинктера
Модная одежда тока бока
Как изменить пароль на почте на айфоне
Число базофилов 143 фотографий